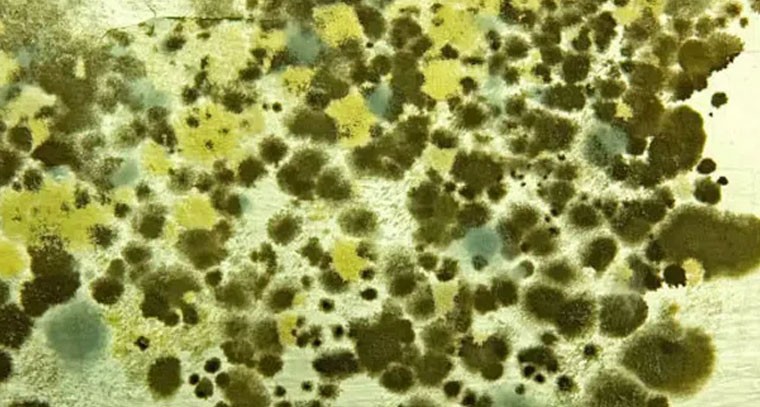

ట్రెండింగ్
మనిషికి సోకిన వృక్ష శిలీంధ్రం
national | Suryaa Desk | Published : Sat, Apr 01, 2023, 12:04 PM
కాలక్రమేనా అనేక వ్యాధులు మానవజీవితాన్ని విచ్ఛిన్నం చేస్తున్నాయి. తాజాగా వృక్షజాతుల్లో సిల్వర్ లీఫ్ అనే వ్యాధికి కారణమయ్యే కొండ్రోస్టీరియం పోర్పోరియమ్ శిలీంధ్రం తొలిసారి అదీ భారత్లోనే ఓ వ్యక్తికి సోకింది. ప్రపంచంలోనే ఈ తరహా తొలి కేసు ఇదే కావడం గమనార్హం. కోల్కతాకు చెందిన వృక్ష సంబంధిత శిలీంధ్రాలపై పని చేసే ఓ పరిశోధకుడి ఈ వ్యాధి సోకగా సర్జరీ చేసి మెడ వద్ద కణతి తొలగించారు.

|

|
